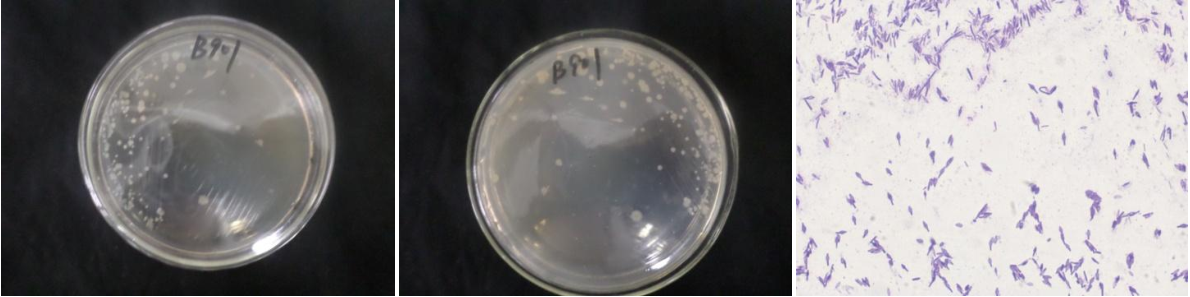

Loading...
| StrainNO | B901 |
| Classification | Salirhabdus |
| 16s rDNA sequence | CCCCGTGATGCTCTTGTTCGACTTCACCCCAATCATCTGTCCCACCTTAGGCGGCTGGCTCCTTACGGTTACCCCACCGACTTCGG GTGTTACAAACTCTCGTGGTGTGACGGGCGGTGTGTACAAGGCCCGGGAACGTATTCACCGCGGCATGCTGATCCGCGATTACTAG CGATTCCGGCTTCATGCAGGCGAGTTGCAGCCTGCAATCCGAACTGAGAATGGTTTTATGGGATTGGCTTGACCTCGCGGTCTTGC AGCCCTTTGTACCATCCATTGTAGCACGTGTGTAGCCCAGGTCATAAGGGGCATGATGATTTGACGTCATCCCCACCTTCCTCCGG TTTGTCACCGGCAGTCACCTTAGAGTGCCCAACTGAATGCTGGCAACTAAGATCAAGGGTTGCGCTCGTTGCGGGACTTAACCCAA CATCTCACGACACGAGCTGACGACAACCATGCACCACCTGTCACTTCGTCCCCCGAAGGGGAACCTTCTATCTCTAGAAGTAGCGA AGGATGTCAAGACCTGGTAAGGTTCTTCGCGTTGCTTCGAATTAAACCACATGCTCCACCGCTTGTGCGGGCCCCCGTCAATTCCT TTGAGTTTCAGTCTTGCGACCGTACTCCCCAGGCGGAGTGCTTAATGCGTTTGCTGCAGCACTAAAGGGCGGAAACCCTCTAACAC TTAGCACTCATCGTTTACGGCGTGGACTACCAGGGTATCTAATCCTGTTCGCTCCCCACGCTTTCGCTCCTCAGCGTCAGTTACAG ACCAGAGAGTCGCCTTCGCCACTGGTGTTCCTCCACATCTCTACGCATTTCACCGCTACACGTGGAATTCCACTCTCTCTTCTGCA CTCAAGTTCCCCAGTTTCCAATGACCCTCCACGGTTGAGCCGTGGGCTTTCACATCAGACTTAAGAAACCGCCTGCGAGCGCTTTA CGCCCAATAATTCCGACAACGCTTGCCACCTACGTATTACCGCGCTGCTGCACGTAGTTAGCGTGGCTTTCTGTTAGTACGTCAAG GTACAGCAGTTACTCTGTACTTGTTCTTCATAACAACAGAACTTTACGACCGAGCTTCATCGGTCACGCGGGTGCTCGTCGACCTT CGTCATTGGCGAAGAATCCTTATCTGTCATAGCTTCCGTAGACTCTGGCCGGTTCAAGTCCATGCAATACCCTTCAGTGCCTACGA TCGTGCCCTTGTGGAGAAGACT |
| Strain Morphology Photos | |
| Morphological Description | Colony round;milky white;Marginal hypodontia;Slightly convex;have concentric rings;convex in the middle;slippy;sticky;Rod;having spore;Bacteriophage telogen |